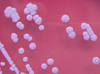

|
실리콘 양자점 인체 진단용 조영제 가능성 열려 ...
|
2013/08/15 |
|
실리콘 양자점 인체 진단용 조영제 가능성 열려 || 유방암을 타깃으로 한 면역계 활성 나노약물 || 뉴런, 기억에도 관여-파킨슨병 등 규명에 도움 || 치명적 로타바이러스에 대한 항체를 함유한 유전자조작 쌀 || 산양산삼의 당뇨병 개선효과 입증 || 아동 천식 및...
|
|

|
그 온도가 내 입맛에 꼭 맞아! ...
|
2013/08/15 |
|
그 온도가 내 입맛에 꼭 맞아! || 死後 세계 봤다? 뇌파 폭발 때문 - 심장 박동 멈춘 뒤에도 뇌파 잠시 동안 요동쳐 || 산업용 미생물 균주 대량생산 기술 개발 - 다양한 화학원료 만드는데 큰 역할 || 보다 안전하고 효과적인 살모넬라 기반 백신의 설계 ||...
|
|

|
사람처럼 농사를 짓는 아메바 - 아메바와 박테리아의 공생 관계...
|
2013/08/14 |
|
사람처럼 농사를 짓는 아메바 - 아메바와 박테리아의 공생 관계 || 일본산 수입 날개 다랑어 '세슘' 검출 || 한국 파스퇴르연구소, 결핵균의 증식을 막는 새로운 합성 분자 개발 || 잠 못 자면 살찌는 이유 밝혀 || 강직성척추염 새 발병원인 규명 || 왜...
|
|

|
박테리아로 박테리아 제압한다 ..
|
2013/08/13 |
|
박테리아로 박테리아 제압한다 || 생 마늘, 폐암 예방에 좋다는 데 찐 마늘은? || 당신의 성격, 엄마 배속에서 이미 결정 || 레이저 진동 분석해 남은 수명 측정하는 기술 개발 || 박테리아 이용한 슈퍼커패시터용 전극 합성공정 개발 || 난치성 결핵 새로운 약...
|
|
|
세포분열의 동력 원천 규명 ...
|
2013/08/05 |
|
세포분열의 동력 원천 규명 || 미생물군 유전체 프로젝트 제 2단계 실행문제 || 세포 모방 리튬이차전지 개발 가능성 확인 || 박테리아 이용 차세대 충전지 전극재료 개발 성공 || 감염에 좀더 취약한 여성 || 새의 뇌가 새보다 먼저 등장일부 공룡, 시조새보다 ...
|
|
|
